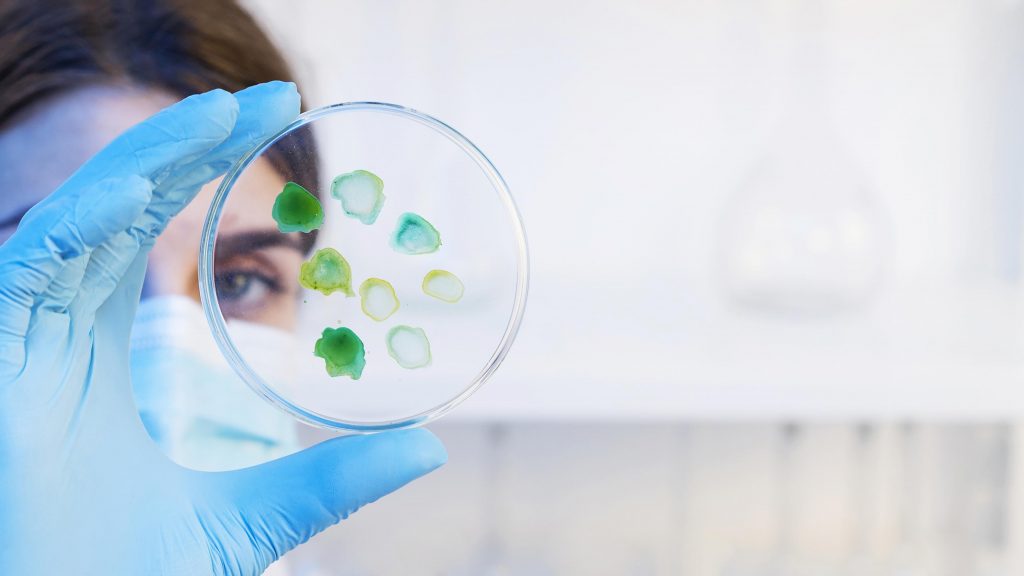

Aprueban en Colombia terapia celular con tratamiento chileno
En este artículo
Tras un año de ensayos clínicos, la biotech chilena Cells for Cells -vinculada a la Universidad de Los Andes– probó la eficacia de su producto biológico para artrosis de rodilla, Cellistem®OA, en el mercado colombiano, paso previo para iniciar su comercialización.
Cells for Cells -la mayor empresa de biotecnología público-privada de América Latina dedicada a la investigación, desarrollo y comercialización de terapias celulares- estableció una alianza estratégica con la clínica FOSCAL de Colombia en 2021 que le permitió ingresar a ese país y partir con las pruebas clínicas completando un Ensayo Clínico Controlado Fase II.
Estas incluyeron a 30 pacientes con artrosis de rodilla, los que tras ser inyectados con Cellistem –o con corticoides intraarticulares- presentaron resultados altamente positivos luego de un año de seguimiento.
“Los pacientes que recibieron la terapia celular demostraron un mejor perfil de eficacia, con menos dolor y mayor funcionalidad al final del seguimiento. Con estos resultados, se espera durante las próximas semanas mantener una reunión con la agencia regulatoria local, el Instituto Nacional de Vigilancia de Medicamentos y Alimentos (INVIMA), para avanzar con miras a expandir el uso de Cellistem en Colombia”, explica el director médico de Cells for Cells, Francisco Espinoza.
La operación en ese país incluyó la transferencia de tecnología realizada íntegramente en Chile, incluyendo la donación de las células de cordón umbilical, las que fueron aisladas y multiplicadas para ser inyectadas en los pacientes colombianos.
Alta prevalencia
La artrosis es una enfermedad que afecta a millones de personas en todo el mundo y no tiene, hasta ahora, un tratamiento eficaz. Lo notable es que la incidencia en pacientes jóvenes de entre 35 y 44 años ha aumentado cuatro veces desde 1990 a la fecha, sobre todo debido a la obesidad, pero también a actividades como la práctica de deportes extremos o de alto impacto como el crossfit.
“Cellistem mostró una reducción del dolor de hasta un 86% en pacientes con osteoartritis de rodilla leve a moderada y mejoró la funcionalidad de las articulaciones en aproximadamente un 89%, siendo la mejor opción costo-beneficio hasta la fecha”, afirmó el director científico de Cells for Cells, Maroun Khoury.
En Colombia, según los datos de la Asociación de Reumatología, 1 de cada 4 personas sufren de osteoartritis, siendo la enfermedad reumática más prevalente en ese país.
“Considerando las cifras, la relevancia de este estudio clínico fue determinar la seguridad y eficacia de este nuevo abordaje terapéutico en nuestra población, y de esta manera contar con una terapia más efectiva para este padecimiento. Con nuestros hallazgos, no cabe la menor duda de que Cellistem podría ser utilizado para el tratamiento de la osteoartritis en nuestro país”, señaló Martha Ligia, directora científica de terapias avanzadas de FOSCAL.
Se espera que una vez aprobada por la agencia INVIMA la comercialización de la terapia chilena comience durante el primer semestre del próximo año en Colombia.
*Fuente: Cooperativaciencia.cl
Si te gustó, ¡compártelo!
Artículos relacionados

¡Conoce nuestro Centro de Salud de San Bernardo (CESA)!
13 de Febrero de 2023

¿Cómo atender adecuadamente a pacientes en situación de discapacidad?
09 de Febrero de 2023

¿Qué beneficios te entrega estudiar un Diplomado en Enfermería Oncológica?
12 de Mayo de 2023

Bootcamp Autismo 360º: Una formación completa por primera vez en Chile
28 de Julio de 2023